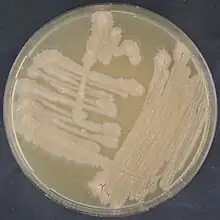

Tsukamurella tyrosinosolvens
| Tsukamurella tyrosinosolvens | |
|---|---|
| Scientific classification | |
| Domain: | Bacteria |
| Phylum: | Actinomycetota |
| Class: | Actinomycetia |
| Order: | Mycobacteriales |
| Family: | Tsukamurellaceae |
| Genus: | Tsukamurella |
| Species: | T. tyrosinosolvens |
| Binomial name | |
| Tsukamurella tyrosinosolvens Yassin et al. 1997[1] | |
| Type strain[2] | |
| CCUG 38499, CIP 106771, DSM 44234, IFM 810, IMMIB D-1397, JCM 10112, KCTC 19177, KCTC 9965, PCM 2579 | |
| Synonyms | |
| |
Tsukamurella tyrosinosolvens
Tsukamurella tyrosinosolvens is a Gram-positive and aerobic bacterium from the genus Tsukamurella.[1][2][3] Tsukamurella tyrosinosolvens bacteria can cause in rare cases infections in humans.[4][5]
References
- 1 2 Yassin, A. F.; Rainey, F. A.; Burghardt, J.; Brzezinka, H.; Schmitt, S.; Seifert, P.; Zimmermann, O.; Mauch, H.; Gierth, D.; Lux, I.; Schaal, K. P. (1 July 1997). "Tsukamurella tyrosinosolvens sp. nov". International Journal of Systematic Bacteriology. 47 (3): 607–614. doi:10.1099/00207713-47-3-607. PMID 9226890.
- 1 2 Parte, A.C. "Tsukamurella". LPSN.
- ↑ Karunakaran, R.; Halim, H. A.; Ng, K. P.; Hanifah, Y. A.; Chin, E.; Jaafar, F. L.; Abubakar, S. (1 November 2011). "Tsukamurella tyrosinosolvens intravascular catheter-related bacteremia in a haematology patient: A case report". European Review for Medical and Pharmacological Sciences. 15 (11): 1343–1346. ISSN 1128-3602. PMID 22195371.
- ↑ Sheng, W.-H.; Huang, Y.-T.; Chang, S.-C.; Hsueh, P.-R. (18 March 2009). "Brain Abscess Caused by Tsukamurella tyrosinosolvens in an Immunocompetent Patient". Journal of Clinical Microbiology. 47 (5): 1602–1604. doi:10.1128/JCM.01932-08. PMC 2681870. PMID 19297591.
- ↑ Ménard, Armelle; Degrange, Sébastien; Peuchant, Olivia; Nguyen, Thi; Dromer, Claire; Maugein, Jeanne (2009). "Tsukamurella tyrosinosolvens - An unusual case report of bacteremic pneumonia after lung transplantation". Annals of Clinical Microbiology and Antimicrobials. 8 (1): 30. doi:10.1186/1476-0711-8-30. PMC 2780973. PMID 19909497.
Further reading
- Sheridan, Elizabeth A. S.; Warwick, Simon; Chan, Anthony; Antonia, Martino Dall’; Koliou, Maria; Sefton, Armine (March 2003). "Tsukamurella tyrosinosolvens Intravascular Catheter Infection Identified Using 16S Ribosomal DNA Sequencing". Clinical Infectious Diseases. 36 (5): e69 – e70. doi:10.1086/367654. PMID 12594657.
- George M., Garrity (2012). Bergey's manual of systematic bacteriology (2nd ed.). New York: Springer Science + Business Media. ISBN 978-0-387-68233-4.
External links
This article is issued from Wikipedia. The text is licensed under Creative Commons - Attribution - Sharealike. Additional terms may apply for the media files.